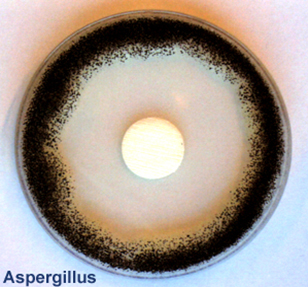

Publicado el 21-11-2018 por Fakolith Chemical Systems
Existen sectores alimentarios donde el control de hongos y bacterias en sus instalaciones es una prioridad absoluta de seguridad alimentaria, por ejemplo, el sector cárnico y del pescado, entre otros, donde estos microorganismos pueden causar toxinfecciones alimentarias.
Este no es el caso de las bodegas, debido a la naturaleza del vino, donde la seguridad alimentaria no se ve comprometida por microorganismos patógenos.
Ahora bien, durante el proceso de vinificación y crianza del vino pueden aparecer otros microorganismos indeseados, ya sea desde la materia prima, de superficies y del ambiente de la bodega o puede ser debido también a las condiciones tecnológicas de la fermentación del mosto y almacenamiento del vino.
Existen 2 importantes riesgos asociados a la existencia de hongos levaduras y bacterias no deseadas en bodegas, que nuestras tecnologías pueden convertir en mejoras:
1.- La contaminación organoléptica de la producción (Carácter Brett, TCA, MFL, OACF, TDN…) puede causar graves pérdidas económicas y de imagen a los bodegueros, al tener que retirar partidas enteras de vino con alteraciones de aroma, aspecto ó gusto.
2.- En algunos casos, la no calidad e higiene del ambiente y superficies existentes en bodegas, se pueden transformar en vectores de contaminación del vino y las personas.
Fakolith con sus tecnologías BioFilmStop y sus sistemas específicos desarrollados para estos casos, contribuye muy positivamente a evitar o reducir drásticamente, estos dos riesgos apuntados.
Y por último pero no menos importante es la obligatoriedad del bodeguero de cumplir con las regulaciones de contacto directo con alimentos que controlan la transmisión de tóxicos desde las superficies de depósitos al vino. Están definidas en la norma UE 10/2011, la reciente 2018/213 y todas las asociadas. Este aspecto, ha sido tratado en nuestro blog anterior con detalles y soluciones de nuestra tecnología FoodGrade, pero si necesitan más información nos pueden consultar en nuestro especial “Renovación depósitos de vino con pintura alimentaria”.
En cada bodega existe una biótica y no es posible trabajar en un entorno estéril, por lo tanto todo lo que sea prevenir las posibles contaminaciones del entorno de la bodega al vino, es una decisión acertada.
Si le interesa conocer soluciones a estos problemas endémicos del sector vinícola (entre otros), Fakolith les puede ayudar a solucionarlos y prevenirlos desde www.pinturaalimentaria.es. Siga leyendo para más información.
1.- Un entorno ideal para el crecimiento de microorganismos en múltiples superficies
Si definiéramos las condiciones del ambiente ideal para la anidación y crecimiento exponencial de mohos, levaduras y bacterias, un buen ejemplo sería un entorno con:

• Elevada humedad ambiental
• Elevada humedad en superficies
• Condensaciones
• Filtraciones
• Ventilación insuficiente
• Temperatura idónea
• Nutrientes orgánicos
Es decir, el ambiente y entorno que generalmente se da en una Bodega.
2.- Las pinturas y tratamientos convencionales agravan la situación
Hay que ser conscientes que el bodeguero ha probado diferentes soluciones, siendo una de las más habituales las “pinturas antimoho o anti-humedad” convencionales, que si bien algunas funcionen en determinados ambientes domésticos, no son productos pensados para proporcionar una solución efectiva y duradera a la industria. Muchos bodegueros ya han comprobado que tras pintar con este tipo de pinturas, al cabo de pocos meses, el problema reaparece y se agrava alimentando la infección, por lo que es de entender que muchos bodegueros optaran por no pintar más, dada la ineficacia conseguida.
En cambio la gama de pinturas alimentarias y sanitarias con tecnología BioFilmStop de Fakolith han demostrado su eficacia en Bodegas, en las condiciones más severas.
3.- Riesgo de contaminación organoléptica
¿Quién no ha descorchado alguna vez una botella de vino con inusual turbidez, aroma o gusto desagradables?
Estas alteraciones organolépticas son causadas por la existencia de metabolitos de determinados microorganismos indeseables, mohos, levaduras y bacterias en bodegas:
• MOHOS: En algunos casos, se introducen ya a través de la materia prima y utensilios, así como del ambiente típico de la bodega, donde colonizan y se multiplican en pavimentos, paredes, techos, etc., para luego llegar a contaminar circuitos cerrados, depósitos, embotellados, etc.
Uno de los responsables principales es el típico sabor a corcho o TCA (Tricloroanisol), producido por metabolitos de mohos filamentosos (Aspergillus, Penicillium, Cladosporium...)
• LEVADURAS Y BACTERIAS: Pueden producir enturbiamiento, aromas de animales, sudor de caballo, establo... Son debidos a la presencia en el vino de etilfenoles volátiles, a causa del metabolismo de las levaduras contaminantes, Brettanomyces / Dekkera, y algunas cepas de Pediococus y Lactobacilos.
El aumento del ácido acético se debe a bacterias acéticas Acetobacter. Una afectación sensorial que recuerda a la orina de ratón es debida a levaduras Brettanomyces / Dekkera y también a bacterias lácteas.
También se asocia el aroma de petróleo, queroseno y naftaleno en el vino por la aparición de TDN (Trimetildihidronaftaleno) debido la degradación de los carotenos de la uva por la presencia de levaduras o bacterias con capacidad enzimática.
Los mohos y las levaduras, son visibles en múltiples superficies de las bodegas, paredes, techos y otras superficies, contaminando superficies y ambiente con esporas, micotoxinas, etc. que finalmente pueden llegar a contaminar el vino. Las bacterias no son visibles, pero están generando importantes biofilms.
4.-Riesgos para la salud de los mohos en edificios en general
Un grupo de turistas japoneses se negó a continuar la visita a una bodega por la presencia evidente de mohos en las paredes. No podían entender su existencia masiva en una instalación alimentaria.
Está demostrado que la exposición permanente a mohos, levaduras y bacterias en los edificios, pueden causar diversos tipos de micosis y enfermedades y bajas laborales, que van desde alergias, rinitis, sinusitis o molestias leves, a graves problemas de salud especialmente en personas inmunodeprimidas.
Si desea información detallada lea este informe sobre “Mohos y bacterias en nuestros edificios”.
Afortunadamente este problema sí tiene solución efectiva y duradera.
5.- Soluciones básicas en bodegas
Luchar contra las humedades y sus consecuencias es una tarea prioritaria en una bodega, porque a parte de deteriorar las superficies, es uno de los ingredientes vitales que favorecen la anidación y crecimiento de mohos levaduras y bacterias.
Consejos habituales por ejemplo serían:
- Mantener secos en lo posible los suelos en las zonas de crianza de vinos
- Evitar en lo posible las salpicaduras en paramentos y paredes.
- Mantener debidamente aislado el corcho de las botellas.
- Proteger los materiales orgánicos sensibles a la humedad como la madera.
- Aislar y retirar packaging húmedo de cartón, madera, palets, etc. de las zonas de crianza.
- Disponer de sistemas de ventilación adecuados.
- Mantener la máxima higiene posible.
6.- Solución con Pinturas Alimentarias y Sanitarias e Hidrofugantes de superficies con tecnología BioFilmStop
Como hemos dicho antes, el entorno de la bodega no es estéril, sino que existe una biodiversidad microbiológica importante con fermentaciones y abundantes nutrientes.
Además los resultados finales de la fermentación dependen de las condiciones técnicas que marcan los enólogos.
Por todo ello es importante aplicar factores de prevención en el entorno de la bodega, donde si podemos actuar para neutralizar la contaminación o impedir que se produzca en:
a) Paredes, paramentos, techos y pavimentos.
b) Estructuras de madera, vigas, jaulones de botellas etc...
c) Exterior de barricas.
d) Zonas de piedra natural o mortero, hormigón, cerámica...
e) Estructuras metálicas.
f) Y como consecuencia de los puntos anteriores, en el ambiente de la bodega.
Gracias a la especialidad de nuestros productos Fakolith tratados con la continuamente renovada Tecnología BiofilmStop, disponemos de soluciones de larga duración para todo tipo de superficies abiertas, que en realidad representan más del 90% de las superficies de las bodegas.
BioFilmStop se aplica en forma de pinturas tratadas (BPR Art. 3) y tratamientos de superficies, en paredes, techos, suelos y otras superficies pintables y transforma estas superficies que son vectores de contaminación potencial, en superficies activas inhibidoras de la contaminación.
Las ventajas principales son definitivas:
• La inhibición de biofilm, bacterias, mohos etc., es estática, sin liberar biocidas al ambiente.
• La inhibición es activa durante las 24h del día, 365 días al año, y durante años.
• Es efectiva e inocua en presencia de alimentos y personas.
• Aplicable mientras se sigue con la actividad de la bodega.
• Aplicación a gran variedad de temperaturas, alta humedad, con bajo olor.
• Proporciona un entorno laboral más seguro con menor riesgo de bajas laborales.
Las principales soluciones para el sector vinícola contra la humedad y sus consecuencias son:
• Pinturas sanitarias y alimentarias para Paredes y techos afectados de mohos y microorganismos.
• Hidrofugación incolora y sin capa, de superficies minerales tales como, piedra natural y artificial, hormigón, morteros, cerámica, etc...
• Barnices alimentarios transpirables para proteger el exterior de las barricas, vigas, paramentos y otras superficies de madera.
• Pinturas para superficies metálicas de todo tipo.
7.- El valor añadido que aporta Fakolith
Fakolith es una empresa pionera en pinturas alimentarias y sanitarias. SI bien nuestra firma tiene más de 50 años, fue en 2009 cuando nuestra inquietud por la higiene y seguridad alimentaria nos llevó al desarrollo de las innovadoras tecnologías FoodGrade y BioFilmStop. Desde entonces nos hemos posicionado como el primer fabricante del sector que cumple con todas las regulaciones vigentes y aplicables a esta nueva especialidad, aportando a nuestros clientes un gran valor añadido:
I+D+i Oficial de pinturas alimentarias y sanitarias.Gran variedad de barnices y pinturas alimentarias y sanitarias.8.- Links de interés
Folleto Pinturas alimentarias y sanitarias certificadas
Post renovación de depósitos en bodegas
Suscríbase a nuestro boletín de noticias técnicas y permanezca informado